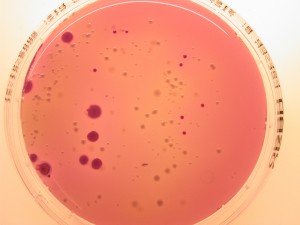

Undersøgelse for colibakterier
Hvis der har været oversvømmelse i en bygning, og man ønsker at fastslå, om der er tale om kloakvand eller almindeligt regnvand, kan man undersøge for colibakterier og andre tarmbakterier ved at udtage en prøve.
Prøven udtages med en speciel kontaktskål, som via en farvereaktion kan påvise colibakterier og andre tarmbakterier, der findes i kloakvand.
Kontaktskålen kan rekvireres hos os, og returneres med det samme efter prøvetagning, helst ved indlevering i laboratoriet samme dag. Prøven udtages ved aftryk på den inficerede overflade. Der følger en vejledning med. Prøvesvaret foreligger dagen efter vi har modtaget prøven.
Efter endt analyse udfærdiges der en rapport, som sendes pr. e-mail. Man kan også få et mundtligt svar pr. telefon, hvis det haster meget med svaret på om der er colibakterier til stede.
Prøvepris for analyse for colibakterier, se her.